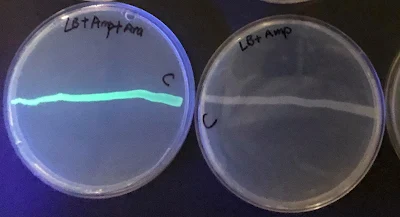

Plasmid
A plasmid is a piece of extrachromosomal DNA present in bacteria that is capable of self-replication [1]. Of microbial species, over 4600 full sequences have been discovered [2]. The plasmid's size varies from 1 to 1000 Kbp and includes only a few genes [3]. Fertility F-plasmids, resistance plasmids, virulence plasmids, degradative plasmids, and col plasmids are the five most commonly known plasmids [3]. They are used as genetic instruments to be injected into bacteria through the transformation mechanism. When inserted into bacterial cells, they are engineered to generate a wide array of stable mRNA that can be converted into protein [1].
Transformation of E. coli
The introduction and expression of foreign DNA in a host organism is referred to as genetic transformation [4-7]. The Gram-negative bacteria Escherichia coli is the most widely used for genetic transformation. DNA uptake and translocation can result in transformation [8]. Having the cells competent is the most common method for transforming DNA into E. coli. The word "competent" refers to the ability to absorb DNA from the surrounding environment. E. coli cells are normally incompetent. However, when exposed to a calcium chloride solution, their cell membranes become competent.
Arabinose Operon
An operon is a collection of genes that are transcribed into RNA by a single promoter [1,6]. Arabinose operon is an example of an operon that metabolizes the basic sugar arabinose [8]. araB, araA, and araD are three clustered genes implicated in the degradation of arabinose. These depend on transcriptional initiation from a single promoter, pBAD. The simultaneous existence of RNA polymerase, a DNA-binding protein called AraC, and arabinose is necessary for transcription.
In the absence of sugar arabinose, the araC binds to the BAD promoter and prevents transcription of digestive enzymes whereas in the presence of the same protein binds to arabinose that leads to a confirmational change to the araC protein. AraB, araA, and araD are then expressed simultaneously and the metabolism of arabinose moves forth till exhaustion [11-13].
Green Fluorescent Protein (GFP)
Green fluorescent protein (GFP) is one of the proteins (about 28KDa) that emit a brilliant green fluorescence when exposed to ultra-violet light [8]. The protein was isolated from Aequorea victoria, a genus of marine jellyfish. The genes that encode GFP have been widely used in cellular and molecular biology as a reporter dye to visualize gene expression, especially in genetic manipulations caused by transformation. Scientists combine the Gfp gene with another gene that makes a protein of interest, then introduce the combination into a cell using DNA recombinant technology. Scientists deduce that the cell expresses the target gene if it emits green fluorescence. GFP is also used by scientists to mark organelles, cells, and tissues. As the GFP gene is inherited, the offspring of tagged organisms likewise glow green.
Characteristics of pGLO Plasmid
The pGLO plasmid is a type of plasmid that has DNA sequences that enable it to replicate and express its fluorescent capability in bacteria after transformation. The pGLO plasmid's important sequences include GFP, ori, bla, the pBAD promotor, araC, and several cloning sites [13]. It means that the pGLO plasmid contains a replication origin, a selectable tag, a gene for Green Fluorescent Protein (GFP), and a gene for the arabinose C protein. The use of reporter genes such as GFP has the distinct benefit of stability, but there is a significant downside in that the device may not be free of artifacts [12].
Interpretation of Result
Photograph 1: Photograph showing the transformation experiments. Left: Green colonies after UV-illumination (LB/AMP/Arabinose with plasmid) and Right: White Colonies after UV radiation (LB/AMP with plasmid).
Picture Credit: Mr. Roshan Timsina (MSc, Public Health Microbiology)
References:
1. Alberts, B., et al. Molecular Biology of the Cell. 6th ed. New Work: Garland Science.
2. https://dx.doi.org/10.3389%2Ffmicb.2015.00242
3. https://www.intechopen.com/books/plasmid/plasmids-as-genetic-tools-and-their-applications-in-ecology-and-evolution
4. https://www.intechopen.com/books/plasmid/plasmids-as-genetic-tools-and-their-applications-in-ecology-and-evolution
5. https://jb.asm.org/content/jb/196/8/1471.full.pdf
6. https://doi.org/10.3791/253
7. https://doi.org/10.1016/B978-012253840-7/50005-5
8. https://doi.org/10.1038/newbio233166a0
9. https://doi.org/10.1111/j.1574-6976.2010.00226.x
10. https://doi.org/10.1016/B978-012253840-7/50005-5
11. https://doi.org/10.1038/newbio233166a0
12. https://doi.org/10.3791/253
13. https://doi.org/10.1111/j.1574-6976.2010.00226.x

No comments:
Post a Comment